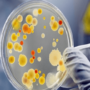
В чем отличия между стафилококком и стафилококковой инфекцией?

Патока, это один из побочных продуктов производства сахара. Также патоку производят из крахмалов разных культур: кукурузы, картофеля, пшеницы, ржи, ячменя и т.п.
Патока, это один из побочных продуктов производства сахара. Также патоку производят из крахмалов разных культур: кукурузы, картофеля, пшеницы, ржи, ячменя и т.п.
Производство патоки – это сложный технологический процесс. Дома этот продукт также можно делать, но это слишком хлопотно и нерентабельно.
Сахар – это искусственный продукт, который изобрели в Индии еще во времена Римской империи. То есть можно сказать, что и сахар, и патока – это далеко не натуральный мед, который люди знали и употребляли со времени своего появления на Земле.
Логично, что их пищевая ценность очень сильно отличается. Наверное, если бы натуральный мед был бы широко доступным, то в сахаре не было бы потребности вообще.
Нужно сказать, что пищевая ценность сахара и патоки также отличаются. Если говорить по-простому, то сахар считается малополезным и даже вредным для здоровья человека.
А вот с патокой ситуация немного другая. Считается, что она даже полезна для здоровья, так как содержит много минералов, микроэлементов и к тому же витаминов группы В.
Где можно употреблять патоку?
Ее используют в производстве кондитерских изделий. Также ее добавляют в тесто для выпечки определенных сортов хлеба. Так как патока имеет способность удерживать влагу, хлебобулочные изделия дольше не черствеют.
Еще одно свойство патоки – низкая температура замерзания. Поэтому ее используют в производстве мороженого. Иначе, оно замерзало бы настолько, что становилось бы просто сладкой ледяной болванкой.
В качестве лечебного средства можно найти информацию, что черная патока (еще называют сырой мелассой) помогает при геморрое.
Объясняется это тем, что черная патока богата на микроэлементы. При этом ее нужно принимать вовнутрь. Более того, утверждается, что некоторым людям употребление этой сырой патоки помогло решить проблему с варикозным расширением вен. Впрочем, геморрой, это одно из проявлений этого недуга (варикоза).
Поскольку черная патока богата на железо, ее рекомендуют употреблять тем, у кого низкий гемоглобин. Еще один приятный бонус от употребления патоки, это то, что от нее лучше растут волосы.
Опять же все дело в минералах и микроэлементах, на которые богат этот продукт. Некоторые знатоки утверждают, что волосы становятся более пышными, патока предупреждает лысение, а также восстанавливает цвет волос.
Также рекомендуется употреблять патоку лицам, страдающим остеопорозом. Это связано с тем, что в этом продукте содержится в необходимом количестве кальций, а также магний, что способствует росту костей. Таким образом, очень полезно употреблять патоку и детям.
Так как черная патока (сырая меласса) очень мало содержит сахара, ее можно использовать людям, больным на сахарный диабет, в качестве заменителя сахара, но все же лучше хорошо исследовать этот вопрос.
Так как патока бывает разная и может иметь разное количество выпариваний (для испарения лишней влаги и этапов очистки сиропа), то и состав ее на предмет сахара может быть разным. Поэтому нужно целенаправленно искать конкретный продукт с конкретным составом. Еще раз хочется напомнить, что видов патоки достаточно много по исходному сырью и по методу производства.
Как видим, патока имеет много полезных свойств. Есть ли какие-то предостережения в отношении этого продукта?
Кроме индивидуальной непереносимости, по сути, нет. Единственно, диабетики должны быть осторожны с этим продуктом, несмотря на то, что в патоке относительно мало сахара, в настоящей патоке. Как всегда, все хорошее должно быть в меру.